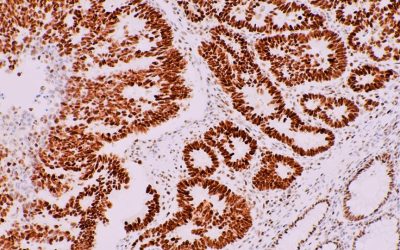
immunohistochemistry-techniques-strengths-limitations-and-applications-363107-960x540
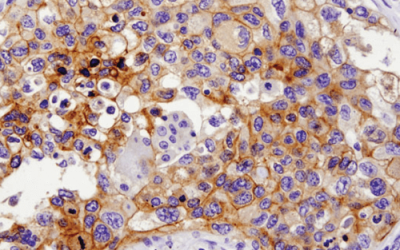
Immunohistochemistry-IHC-13684-PDL1
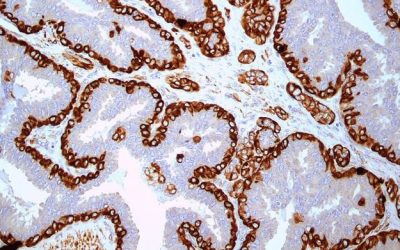
IMG_0275

Το Εργαστήριό μας προσφέρει το μεγαλύτερο φάσμα διαγνωστικών μοριακών εξετάσεων (IVD).
Η διαφορά μας: Αξιοπιστία, ταχύτητα και αυθημερόν αποτελέσματα σε εξετάσεις
RT-PCR και FISH, συμβάλλοντας στην άμεση θεραπεία από τον ογκολόγο.
Με πιστοποίηση από ROCHE Diagnostics
Η ανίχνευση του PD-L1 στο Bioclab πραγματοποιείται με τεχνολογία αιχμής και με πιστοποίηση από τη ROCHE Diagnostics, εξασφαλίζοντας:
Απόλυτη ακρίβεια στη μέτρηση των επιπέδων PD-L1
Αυθημερόν αποτελέσματα για ταχύτερη λήψη θεραπευτικών αποφάσεων
Υψηλή διαγνωστική αξιοπιστία, βασισμένη σε διεθνή πρότυπα
Η εξέταση πραγματοποιείται με το σύστημα Ultra Benchmark Ventana, μία από τις πιο προηγμένες πλατφόρμες στον τομέα της ανοσοϊστοχημείας, και είναι πλήρως εναρμονισμένη με τις οδηγίες των παγκόσμιων επιστημονικών οργανισμών.
Ιδανική για:
Καρκίνο του πνεύμονα
Επιλογή υποψηφίων για ανοσοθεραπείες
Αξιολόγηση βιοδεικτών σε εξατομικευμένη ιατρική
Με την υπογραφή αξιοπιστίας του Bioclab, επενδύουμε στην επιστήμη – υπηρετώντας τη ζωή.

Δυνατότητα εξατομικευμένων εξετάσεων κατόπιν αιτήματος.
Για περισσότερες πληροφορίες πατήστε εδώ
Στο Bioclab πραγματοποιούμε ένα ευρύ φάσμα μοριακών διαγνωστικών εξετάσεων, με χρήση τεχνικών αιχμής όπως RT-PCR και FISH. Οι εξετάσεις αυτές παρέχουν ζωτικής σημασίας πληροφορίες για τη στοχευμένη θεραπεία του ασθενούς και πραγματοποιούνται με αυθημερόν παράδοση αποτελεσμάτων.
Για καρκίνο παχέος εντέρου και μη-μικροκυτταρικό καρκίνωμα πνεύμονος, σε ιστολογικό ή κυτταρολογικό υλικό, με RT-PCR.
Για καρκίνο παχέος εντέρου, με RT-PCR σε ιστολογικό ή κυτταρολογικό υλικό.
Για μη-μικροκυτταρικό καρκίνωμα πνεύμονος, σε ιστολογικό υλικό, με RT-PCR.
Για μελάνωμα, με RT-PCR σε ιστολογικό υλικό.
Μελέτη υπερέκφρασης ή μεταλλάξεων για στρωματικούς όγκους του γαστρεντερικού, με RT-PCR.
Ανίχνευση της αντιμετάθεσης του γονιδίου ALK σε ιστολογικό ή κυτταρολογικό υλικό ειδικά για μη-μικροκυτταρικό καρκίνωμα πνεύμονα.
Κρίσιμη για επιλογή ανοσοθεραπείας.
Για περισσότερες πληροφορίες πατήστε εδώ
Μελέτη γονιδιακής υπερέκφρασης σε καρκίνο μαστού και στομάχου, με FISH.
Για περισσότερες πληροφορίες πατήστε εδώ
Ανίχνευση αναδιατάξεων του γονιδίου PDGFB στη χρωμοσωμική περιοχή 22q13.1 με τη μέθοδο FISH, σε ιστολογικό υλικό παραφίνης.
Χρησιμοποιείται ως βοήθημα στη διαφορική διάγνωση του δερματοϊνοσαρκώματος προεξέχοντος τύπου (DFSP).
Για περισσότερες πληροφορίες πατήστε εδώ
Ανίχνευση της χαρακτηριστικής μετάθεσης t(17;22)(q21.3;q13.1) που αφορά τα γονίδια COL1A1 και PDGFB, με τη μέθοδο FISH, σε ιστολογικό υλικό παραφίνης.
Η εξέταση συμβάλλει στη διαφορική διάγνωση του δερματοϊνοσαρκώματος προεξέχοντος τύπου (DFSP).
Για περισσότερες πληροφορίες πατήστε εδώ
Ανίχνευση ενισχύσεων του γονιδίου MDM2 και χρωμοσώματος 12 σε ALT/WDLPS και DDLPS.
Για περισσότερες πληροφορίες πατήστε εδώ
Η μοριακή εξέταση CDK4/CEN 12 Dual Color Probe (PL61) προορίζεται για τη ποιοτική ανίχνευση των ανευρέσεων (amplifications) που αφορούν το ανθρώπινο γονίδιο CDK4, καθώς και για την ανίχνευση των άλφα δορυφόρων του χρωμοσώματος 12 σε δείγματα όπως άτυπος λιπωματώδης όγκος/καλά διαφοροποιημένο λιποσάρκωμα (ALT/WDLPS) και αποδιαφοροποιημένο λιποσάρκωμα (DDLPS), μέσω φθορίζουσας υβριδοποίησης in situ (FISH).
Ο ανιχνευτής προορίζεται να χρησιμοποιηθεί ως βοήθημα στη διαφορική διάγνωση των ALT/WDLPS και DDLPS.
Για περισσότερες πληροφορίες πατήστε εδώ
Ανίχνευση μεταθέσεων του γονιδίου ROS1 (6q22.1) σε μη-μικροκυτταρικό καρκίνο πνεύμονα.
Για περισσότερες πληροφορίες πατήστε εδώ
Οι μοριακές εξετάσεις με NTRK1/NTRK2/NTRK3 έχουν σχεδιαστεί για την ανίχνευση αναδιατάξεων που επηρεάζουν τις χρωμοσωμικές περιοχές 1q23.1 και 15q25.3, στις οποίες βρίσκονται τα γονίδια NTRK1 (neurotrophic receptor tyrosine kinase 1, γνωστό και ως TRKA, TRK) και NTRK3 (neurotrophic receptor tyrosine kinase 3, γνωστό και ως TRKC), αντίστοιχα.
Τα γονίδια των νευροτροφικών υποδοχέων τυροσινικής κινάσης (NTRK1, NTRK2 και NTRK3) κωδικοποιούν μια οικογένεια υποδοχέων με δραστηριότητα τυροσινικής κινάσης, οι οποίοι διαδραματίζουν σημαντικό ρόλο στην επιβίωση των κυττάρων, στον πολλαπλασιασμό και στη διαφοροποίηση σε υγιή ανθρώπινα κύτταρα.
Οι τύποι όγκων στους οποίους έχουν ανιχνευθεί μετατοπίσεις/συντήξεις των γονιδίων NTRK είναι ποικίλοι και περιλαμβάνουν, μεταξύ άλλων, καρκίνο μαστού, μη μικροκυτταρικό καρκίνο πνεύμονα, σαρκώματα, μελάνωμα και καρκίνωμα θυρεοειδούς.
Η θεραπεία ασθενών με καρκίνους θετικούς για συντήξεις NTRK με αναστολέα NTRK, όπως τα εγκεκριμένα από τον FDA φάρμακα larotrectinib ή entrectinib, σχετίζεται με υψηλά ποσοστά ανταπόκρισης, ανεξάρτητα από το συγκεκριμένο γονίδιο NTRK, τον συνεργάτη της σύντηξης ή τον τύπο του όγκου. Συνεπώς, η ανίχνευση αναδιατάξεων των NTRK1 και NTRK3 με FISH μπορεί να έχει θεραπευτική σημασία.
Η βασική μονοκλωνική αντισωματική θεραπεία για παγκρεατικό καρκίνο που σχετίζεται με NRG1 είναι η zenocutuzumab (Bizengri), ένα δισθενές/διειδικό αντίσωμα που στοχεύει τους υποδοχείς HER2/HER3. Έχει εγκριθεί από τον FDA για τη θεραπεία παγκρεατικού και πνευμονικού καρκίνου με γονιδιακή σύντηξη NRG1, έναν σπάνιο γενετικό οδηγό που προάγει την ανάπτυξη του όγκου μέσω υπερενεργοποίησης της σηματοδότησης του HER3, οδηγώντας σε σημαντικές ανταποκρίσεις σε ασθενείς που ήταν προηγουμένως ανθεκτικοί σε άλλες θεραπείες.
Για περισσότερες πληροφορίες πατήστε εδώ
Με RT-PCR. Ανάλυση περιοχών DMR1 και DMR2 για γλοιοβλάστωμα.
Μεταλλάξεις που επηρεάζουν:
KRAS-WT μεταστατικό καρκίνο παχέος εντέρου
HR-θετικό, HER2-αρνητικό καρκίνο μαστού
Αναλυτικά:
E542K (c.1624G>A)
E545K (c.1633G>A)
E545Q (c.1633G>C)
H1047R (c.3140A>G)
H1047L (c.3140A>T)
Ανίχνευση μεταθέσεων σε:
RET/PTC1
RET/PTC3
PAX8/PPARγ
Κατάλληλο για διαγνωστική διαφοροποίηση καλοηθών όζων από κακοήθεις όγκους.
Ανίχνευση του κυτταρομεγαλοϊού (CMV) με RT-PCR σε ιστολογικό ή κυτταρολογικό υλικό.
Μοριακή ανίχνευση του ιoύ Epstein-Barr (EBV) με RT-PCR σε ιστολογικό ή κυτταρολογικό υλικό, ιδανική για διάγνωση και παρακολούθηση νοσημάτων όπως λοιμώδης μονοπυρήνωση, λεμφώματα και άλλες ιογενείς επιπλοκές.
Ανίχνευση του Mycobacterium tuberculosis με RT-PCR σε ιστολογικό ή κυτταρολογικό υλικό , για την ταχεία διάγνωση της φυματίωσης, ακόμη και σε δείγματα με χαμηλό φορτίο.
Οι ανοσοϊστοχημικές εξετάσεις αποτελούν βασικό εργαλείο για την ακριβή διάγνωση και ταξινόμηση των όγκων. Στο Bioclab, χρησιμοποιούμε εξειδικευμένα αντισώματα και προηγμένη τεχνολογία για την ανίχνευση γονιδιακής υπερέκφρασης, μεταλλάξεων ή πρωτεϊνικής έκφρασης σε ιστικά δείγματα.
Aνοσοϊστοχημική μελέτη μικροδορυφορικής αστάθειας με χρήση των 4 βασικών αντισωμάτων: MLH1, MSH2, MSH6 και PMS2.
Εφαρμόζεται στον καρκίνο παχέος εντέρου για την ανίχνευση MSI status.
Ανοσοϊστοχημική ανίχνευση της πρωτεΐνης ALK (κινάση αναπλαστικού λεμφώματος) σε ιστολογικό υλικό, ειδικά για μη-μικροκυτταρικό καρκίνωμα πνεύμονος.
Κρίσιμη για επιλογή ανοσοθεραπείας.
Ανοσοϊστοχημική μελέτη της υπερέκφρασης του HER2 γονιδίου, απαραίτητη για τη διάγνωση και θεραπεία σε καρκίνο μαστού και καρκίνο στομάχου.
Ανάλυση των υποδοχέων οιστρογόνων (ER) και προγεστερόνης (PR) σε ιστολογικά δείγματα από μαστού και ωοθηκών.
Βοηθά στην αξιολόγηση της καταλληλότητας για ορμονοθεραπεία.
Ανοσοϊστοχημική ανίχνευση λεμφωμάτων μέσω κατάλληλων δεικτών διαφοροποίησης.
Υψηλή εξειδίκευση στην ταξινόμηση υποτύπων λεμφωμάτων.
Το VENTANA PD-L1 (SP263) Assay είναι μία ποιοτική ανοσοϊστοχημική δοκιμασία που χρησιμοποιεί μονοκλωνικό αντίσωμα κουνελιού (clone SP263) έναντι του PD-L1, με σκοπό την αξιολόγηση της έκφρασης της πρωτεΐνης programmed death ligand-1 (PD-L1) σε δείγματα ιστών non-small cell lung carcinoma (NSCLC) που έχουν σταθεροποιηθεί με φορμόλη και ενσωματωθεί σε παραφίνη (FFPE), μέσω οπτικής μικροσκόπησης.
Η δοκιμασία VENTANA PD-L1 (SP263) Assay χρησιμοποιείται σε συνδυασμό με το OptiView DAB IHC Detection Kit για τη χρώση στον αναλυτή BenchMark ULTRA και φέρει σήμανση CE-IVD, κατάλληλη για χρήση ως in vitro diagnostic μέθοδος.
Για περισσότερες πληροφορίες σχετικά με το VENTANA PD-L1 (SP263), πατήστε εδώ.
Ο νευροτροφικός υποδοχέας τυροσίνης κινάσης (NTRK) αποτελεί μία οικογένεια 3 πρωτο-ογκογονιδίων, που περιλαμβάνει τα NTRK1, NTRK2 και NTRK3. Οι μετατοπίσεις (fusions) του γονιδίου NTRK έχουν αναφερθεί σε διάφορους τύπους όγκων και εμπλέκονται σε βιολογικές διεργασίες όπως η επιβίωση, η διαφοροποίηση και η πλαστικότητα των νευρώνων υπό φυσιολογικές συνθήκες. Πρόσφατα, ο FDA έχει εγκρίνει το Entrectinib για ασθενείς με μετατοπίσεις NTRK, επομένως ο έλεγχος για NTRK fusions μπορεί να αναγνωρίσει ασθενείς που ενδέχεται να είναι υποψήφιοι για θεραπεία με αναστολείς NTRK.
Αυτό το πρωτοταγές αντίσωμα έχει βελτιστοποιηθεί και επικυρωθεί χρησιμοποιώντας το σύστημα Ventana BenchMark ULTRA IHC/ISH, το μοντέλο που χρησιμοποιεί και το εργαστήριό μας
Πάνελ IHC για Γαστρικό Καρκίνο (Claudin 18.2, HER2, PD-L1, MMR)
Στο Bioclab διαθέτουμε πλήρες πάνελ διαγνωστικών αντισωμάτων (IVD) για τον γαστρικό καρκίνο, με χρήση της ανοσοϊστοχημείας στο πλήρως αυτοματοποιημένο σύστημα BenchMark Ultra (CE-IVD) της Ventana.
Περιλαμβάνει και την εξειδικευμένη ανίχνευση του Claudin 18.2 (CLDN 18.2) σε δείγματα αδενοκαρκινώματος στομάχου ή γαστροοισοφαγικής συμβολής. Διαβάστε περισσότερα για το Claudin 18.2 και τον ρόλο του στον γαστρικό καρκίνο.
Ειδικός δείκτης για την ανίχνευση του αδενοκαρκινώματος στομάχου και καρκίνου γαστροοισοφαγικής συμβολής.
Καθοριστικός δείκτης για ανοσοθεραπεία.
Υπερέκφραση για στοχευμένη θεραπεία.
Μικροδορυφορική αστάθεια (MSI) σε γαστρικούς όγκους.